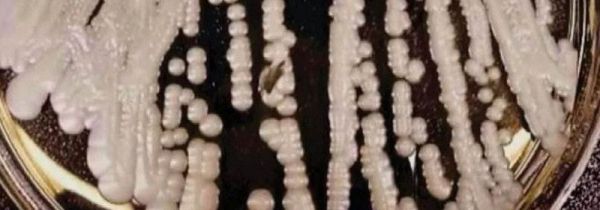
消毒液能杀死真菌吗

消毒液能杀死真菌吗
消毒液不能杀死真菌,消毒液的主要成分是次氯酸钠,它不能用来杀死真菌,只能杀死病毒和细菌,并且真菌多为孢子繁殖,…

七白莲参汤是哪七种
七白莲参汤取材于白灵芝、白人参、白芷、白莲子、名兰、山药、枸杞中草药配方。七白莲参汤的药材主要来自于广西深山,…

七里港是哪里
七里港是浙江省温州市七里港镇的沿海港口,是我国首屈一指的天然深水良港。七里港是国家重点开发的工程项目,以其港区…

消毒液能漂白衣服吗
消毒液可以漂白衣服,但是需要进行稀释,并且浸泡时间不宜太长,以免衣服上有化学物质的残留,对皮肤有所伤害,同时也…

七里香禁忌
孕妇、肠胃不佳和过敏体质者禁止服用七里香。七里香有散气活血、化瘀消肿的作用,孕妇食用可能会导致早产或者流产,肠…

世界三大制冷方式
世界三大制冷方式为蒸发式制冷、吸收式制冷、温差电制冷。蒸发式制冷又叫做功式制冷,制冷能力强,应用广泛,但对环境…

香叶为什么闻没有味道
香叶没有香味,是因为它是月桂树上的叶子,它的精油含量为2%,在未加工前会略带有苦味,但是在加工以后会散发出香味…

空气除湿的方法有哪些
在给空气除湿的时候,可采用通风透气的方法进行,主要是将室内外的空气进行更换,从而让室内进来干燥的空气,或者采用…

除湿器适宜在哪些地区用
一般情况下除湿器适合在沿海地区使用,主要在于上海、四川等地,由于这些地区的空气湿度很大,除湿器可起到改善空气质…

空气除湿器能不能净化空气
一般情况下除湿器不能完全的净化空气,只能对空气的净化有很好的促进作用,它只能改善空气湿度的变化,而部分的加湿器…
